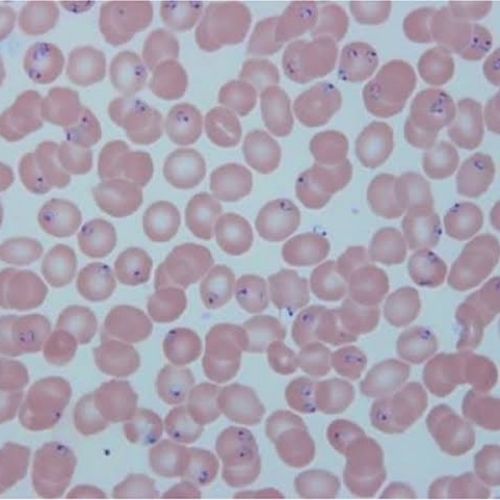
Diagnosis of malaria parasite with floron

Kapillery Malaria Test Kit
Price: 24000.00 INR / Kit Kit
(24000.00 INR + 0% GST)
Get Latest Price
Minimum Pack Size :
1
In Stock
Product Specifications
| Application | Diagnostic use for Plasmodium falciparum and/or Plasmodium vivax |
| Color | White |
| Function | Rapid detection of malaria infection from blood sample |
| Suitable For Use | Hospitals, diagnostic labs, clinics, field testing |
| Equipment Type | Malaria rapid diagnostic test kit |
| Material | Plastic |
| Condition | New |
| Use | Detection of malaria antigens in human blood |
| Payment Terms | Cash Advance (CA), Cash in Advance (CID) |
| Color | White |
| Returnable | No |
| Moq | 1 |
| Price | 24000.00 INR (Approx.) |
| Unit Type | Piece/Pieces |
| Currency | INR |
| Price Type | fixed |
| Brand Name | Florotek Biosystems Pvt. Ltd. |
| Product Unit | 1 Piece/Pieces |
| Stock Quantity | 5 |
| Mop | 1 |
| Minimum Order Quantity | 1 |
| Minimum Ordered Packs | 1 |
| GSTIN | 0% |
Product Overview
Key Features
Company Details
Focusing on a customer-centric approach, Florotek Biosystems Pvt. Ltd. has a pan-India presence and caters to a huge consumer base throughout the country. Buy Medical, Diagnostic & Hospital Supplies in bulk from Florotek Biosystems Pvt. Ltd. at Trade India quality-assured products.
Business Type
Exporter, Manufacturer, Supplier
Employee Count
10
Establishment
2008
Working Days
Monday To Sunday
GST NO
27AFZPD6626B1ZB
Certification
ISO13485, CE, MSME, GST,
Related Products
Explore Related Categories
More Products From This Seller
Seller Details
GST - 27AFZPD6626B1ZB
Dombivli, Maharashtra
Director
Mr. Avinash S. Deshmukh
Address
102, Sonal Palace, Phadke Road Dombivli, Maharashtra, 421201, India
Report incorrect details